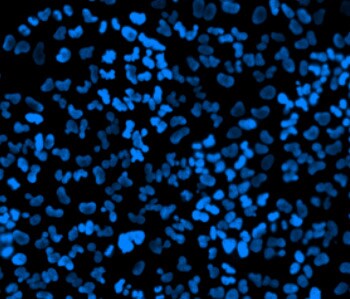
incomplete live-cell nuclear staining incomplete live-cell nuclear staining

Search
Search
![]() | Nucleic acids are the obvious target for nuclear labelingLabeling the nucleus typically relies on some type of dye that binds nucleic acids, and depending on how much distinction you need between DNA and RNA and whether or not the cells you’re labeling are live or fixed, your choice of stains will vary. Learn about the broad classes of nucleic acid stains and review some tips about how to effectively use them. |
The bulk of the content inside the nucleus is nucleic acid, so nucleic acid stains are the obvious choice for nuclear staining. There are two main types of nucleic acid stains: those that will pass through the cell membrane (i.e., cell permeant) and those that will not (i.e., cell impermeant). For most nucleic acid stains, the fluorescent signal is minimal before binding to DNA or RNA, and there is a significant increase in fluorescence intensity after the dye has bound to DNA or RNA.
All nucleic acid dyes have at least some affinity for both DNA and RNA. Some types of nucleic acid dyes are highly specific for the double-stranded DNA (dsDNA) in the nucleus and generate very bright staining in only that region. Other nucleic acid dyes bind both DNA and RNA, resulting in bright nuclear staining as well as some cytosolic staining from dye bound mostly to cytoplasmic RNA and some mitochondrial DNA.
Figure 1. TO-PRO®-3 stain exhibits a bright signal in the nucleus and a dimmer signal in the cytoplasm (from RNA) in fixed and permeabilized U2OS cells.
Figure 2. HUVECs labeled with NucRed™ Live, a cell-permeant nuclear stain.
Cell-permeant nuclear stains can be used to label nuclei in live cells that have intact, nonpermeable plasma membranes. These dyes will also stain nuclei of cells with compromised membranes such as dead cells or cells that have been fixed and/or permeabilized. Examples of cell-permeant nuclear stains include Hoechst stains and SYTO® stains.
Cell-impermeant nucleic acid stains can be used to stain nuclei of cells with compromised membranes such as dead cells (and can act as a dead cell indicator in a viability assay) or cells that have been fixed and/or permeabilized (can be used as a nuclear counterstain for immunolabeling experiments). Cell-impermeant nucleic acid stains will not label live cells that still have intact, nonpermeable membranes. Examples of cell-impermeant nuclear stains include DAPI, propidium iodide, TO-PRO®-3, and SYTOX® stains.
Figure 3. Live and dead HEPG2 cells stained using the LIVE/DEAD® Cell Imaging Kit. Dead cells (red) are labeled with a cell-impermeant dye (DeadRed™ reagent) and live cells (green) are stained with calcein.
Figure 4. Nuclear staining of fixed and permeabilized U2OS cells using NucBlue™ Fixed reagent (a form of DAPI).
If you need to improve the signal:background ratio, there are a few things you can try. You can perform wash steps after you’ve labeled your sample with dye. Washing a few times with complete medium or buffer will help remove unbound or excess dye from your sample. This approach works well when your fluorescent dye is tightly bound to its target and doesn’t dissociate significantly during imaging. Another approach is to image your sample in an optically clear saline-based solution, such as Ringer’s solution, PBS, HBSS, or other clear buffered solutions that will remove the contribution to background fluorescence arising from vitamins and proteins in the culturing medium.
Be aware that if you do not remove some types of high-affinity nuclear dyes during a live-cell assay, the dyes may continue to accumulate in the nucleus and your signal intensity will continue to increase. On the other hand, some live-cell nuclear stains are lower affinity, and the staining solution must be maintained throughout the experiment in order to retain the signal. It’s good to know which type of dye you are using to stain the nuclei of live cells BEFORE you start your experiment!
If you’re working with live cells either to stain all of them (cell-permeant nuclear stains) or just the dead cells (cell-impermeant nuclear stains) you can start checking for fluorescence after 5–15 minutes, but you may need to optimize the incubation time. This usually just means checking on the fluorescence every 10 minutes for up to another 30 minutes following the initial incubation. Be sure to use short exposure times when imaging live cells to avoid photobleaching and phototoxicity. Once you believe that you have a satisfactory signal, you can go ahead and take your final picture, preferably in a field of cells that have not previously been illuminated.
If you’re performing counterstaining after immunofluorescence labeling, your cells are fixed and permeabilized and you’re probably staining in a buffered saline solution, so you can expect them to reach maximum signal intensity after about 5 minutes.
Figure 5. Example of incomplete live-cell nuclear staining. A proportion of the nuclei in these U2OS cells incubated with NucBlue™ Live (a form of Hoechst 33342) don’t exhibit uniform staining (dim regions in the centers of the nuclei). Further incubation is needed to achieve uniform staining of all nuclei.
For Research Use Only. Not for use in diagnostic procedures.